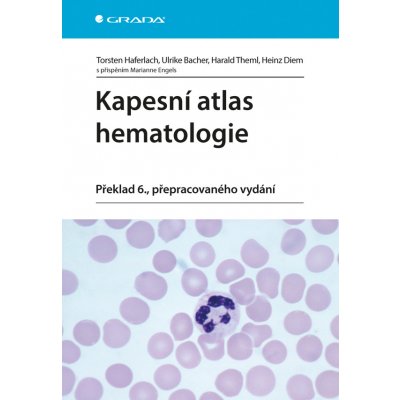
Kapesní atlas hematologie, překlad 6., přepracovaného vydání - Haferlach Torsten, Bacher Ulrike, Thelm Harald, Diem Heinz – Sleviste.cz

Torsten Haferlach ; Ulrike Bacher ; Harald Thelm Překlad 6., přepracovaného vydání GRADA 2014 Kniha, čeština, 232 stran
Koupit za 699 Kč- Nejoblíbenější
- Nejlevnější
- Nejdražší

Kapesní atlas hematologie překlad 6 vydání - Haferlach Torsten Bacher Ulrike Thelm Harald Diem Heinz
Doprava:
69 Kč

Kapesní atlas hematologie
Doprava:
49 Kč
Skladem

Kapesní atlas hematologie - Haferlach Torsten, Bacher Ulrike, Theml Harald, Diem Heinz
Doprava:
39 Kč
Skladem

Kapesní atlas hematologie - Haferlach Torsten
Doprava:
59 Kč
Popis
Torsten Haferlach ; Ulrike Bacher ; Harald Thelm Překlad 6., přepracovaného vydání GRADA 2014 Kniha, čeština, 232 stran
Parametry
| Autor | Haferlach Torsten a kolektiv |
| Jazyk | české |
| Nakladatelství | Grada |
| Rok vydání | 2014 |
| Vydavatel | GRADA |
| Výrobce | GRADA |
| Počet stran | 232 |